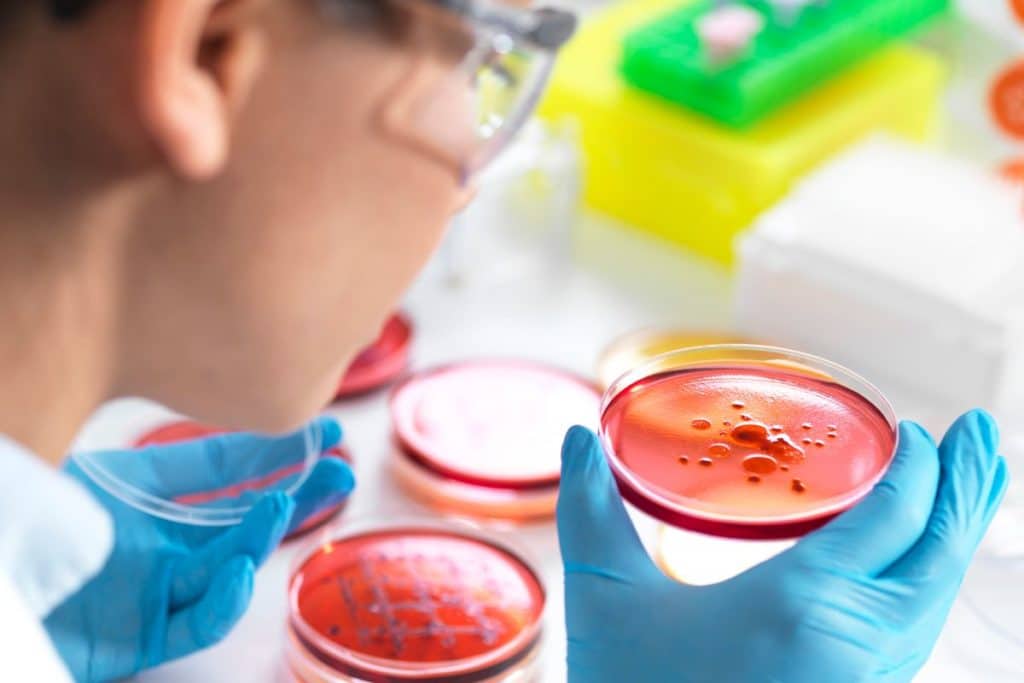
Microrganismos são capazes de degradar poluente de esgoto altamente tóxico

Microrganismos eliminam o tetrabromobisfenol A (TBBPA), aditivo usado para evitar chamas em plásticos e tecidos e que no meio ambiente apresenta efeitos tóxicos e cancerígenos

“Biossistemas anaeróbios são aqueles nos quais microrganismos consomem a matéria orgânica sem a presença de oxigênio dissolvido no meio”, explica o professor Marcelo Zaiat, da EESC, orientador do trabalho.
“Vários grupos microbianos, por meio de respiração anaeróbia ou fermentação, atuam neste sistema, que se dá em várias etapas metabólicas, tendo como produto o biogás, composto majoritariamente por metano e dióxido de carbono.” Williane Macêdo relata os efeitos nocivos do poluente analisado no trabalho.
“O TBBPA é um aditivo retardante de chama, ou seja, ele é aplicado a diversos materiais para reduzir a propagação de chama em materiais como plásticos, tecidos, móveis, eletrônicos, materiais de construção civil, encanamentos, entre outros”, observa ela.
“O poluente se desprende das superfícies com o desgaste natural dos produtos e chega até o ar, poeira, e demais superfícies, atingindo assim as redes de esgotos.” Segundo a pesquisadora, o TBBPA interfere nos seres vivos, sendo causador de efeitos tóxicos nos sistemas imunológico e nervoso em organismos aquáticos, e ligado ao desenvolvimento de câncer em estudos feitos com ratos. “Este composto é também associado à mutação genética em sapos e fica acumulado no tecido de peixes”, salienta.
“Porém, a aplicação destas tecnologias especificamente para a degradação de micropoluentes como o TBBPA ainda requer avanços científicos que estão sendo estudados”, observa.
“O objetivo da pesquisa foi entender como os aditivos aplicados a diversos materiais do dia a dia, especialmente plásticos, afetam o meio ambiente e como as tecnologias de engenharia e biologia molecular podem ser usadas para solucionar o problema da poluição ambiental.”
Degradação do poluente
Para identificar os microrganismos que degradam o TBBPA, a pesquisa então usou uma combinação de técnicas de biologia molecular.
“Inicialmente, nós extraímos e sequenciamos o DNA de uma biomassa, que é uma população composta de milhares de organismos diferentes, exposta ao esgoto doméstico simulado, contendo TBBPA. Nós monitoramos em paralelo a degradação do composto e o desenvolvimento deste ecossistema microbiano”, descreve Williane Macêdo. “Em seguida, unimos essas duas informações, através de uma técnica conhecida como sequenciamento do gene 16SrRNA, para sugerir que grupos deste ecossistema estavam atuando na degradação do TBBPA, e foram ou não afetados por ele.”
“Em seguida, nós adquirimos o TBBPA ‘confeccionado’ com carbonos marcados, ou seja, átomos de carbono que podíamos identificar, com técnicas analíticas, que são provenientes dele. Então, a biomassa foi alimentada com o TBBPA-marcado e as proteínas produzidas na atividade metabólica dos organismos que tinham o carbono-marcado foram identificadas e conectadas diretamente a microrganismos específicos”, aponta a pesquisadora. “Por exemplo, a proteína A possuía carbono proveniente do TBBPA-marcado, e foi produzida no metabolismo do organismo X. Desta forma, sugerimos que o organismo X ‘consumiu’ o TBBPA-marcado”.
A pesquisa então concluiu que a combinação da química analítica, engenharia de reatores e biologia molecular resultou no avanço científico na degradação de micro poluentes.
“Esta técnica representa o estado da arte da biotecnologia e é a combinação do sequenciamento genômico de uma cultura complexa, a metagenômica; da análise global das proteínas expressas, metaproteômica; e da protein-SIP, do inglês, Protein Stable Isotope Probing”, diz Williane Macêdo. “Os resultados sugerem que os microrganismos anaeróbios são capazes de degradar retardantes de chama como o TBBPA e como essas tecnologias devem ser otimizadas para maximizar a degradação de poluentes e, consequentemente, trazer maior segurança ambiental.”
“Este trabalho foi pioneiro e investigatório, dessa forma, é necessário responder às perguntas que a pesquisa gerou e aprofundar o conhecimento nas técnicas utilizadas. A pesquisa de base antecede a aplicada, dessa forma, a ampliação de escala dos reatores, por exemplo, é necessária para poder se falar em aplicação de tecnologia em escalas reais”, comenta a pesquisadora. De acordo com o professor Zaiat, “a importância do estudo está, principalmente, na proposição de sistemas de tratamento de águas residuárias não focados apenas na remoção de matéria orgânica e nutrientes, como os sistemas convencionais, mas na retirada adicional de micropoluentes ou poluentes emergentes, que podem causar grandes impactos ambientais.”
O professor Marcelo Zaiat, da EESCA orientou a pesquisa. O professor Jeppe Lund Nielsen, da Aalborg University, supervisionou parte do trabalho desenvolvido na Dinamarca. O estudo teve financiamento da Fundação de Amparo à Pesquisa do Estado de São Paulo (Fapesp).
Fonte: labnetwork
LEIA TAMBÉM: CIENTISTAS CHAMAM A ATENÇÃO PARA DOENÇAS NEGLIGENCIADAS, QUE SÃO IGNORADAS PELA INDÚSTRIA FARMACÊUTICA